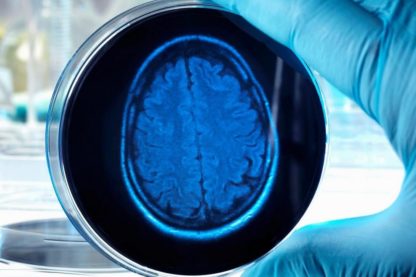
cerveaux humains culture élevage étude biologie médecine

Des chercheurs chinois développent un bio-ordinateur intégrant des organoïdes cérébraux humains à une puce dans le but de contrôler des...
840 résultat pour
cerveau humain
Cela fait maintenant des décennies que les scientifiques cherchent à reproduire le fonctionnement du cerveau humain afin d’en exploiter les...
Le cerveau, centre de contrôle de notre corps, est difficile d’accès et donc difficile à étudier, encore plus dans le...
Chaque organe du corps humain est constitué d’un tissu cellulaire spécialisé remplissant les fonctions physiologiques nécessaires. Ces tissus ont majoritairement...
Une étude unique en son genre : des chercheurs ont effectué des scans IRM de cerveaux provenant de 130 mammifères...
L’intelligence humaine est l’une des plus spectaculaires, mais également l’une des moins comprises. La conséquence d’un évolution qui a commencé...
Plus de 2000 cerveaux humains stockés dans des banques de tissus abandonnent à présent leurs secrets génétiques ! Des analyses du...
Une scientifique de l’Université de Cambridge a réussi à développer 300 cerveaux en laboratoire, à partir d’échantillons de peau humaine. Le but de...
Des chercheurs ont créé des neurones spécialisés dérivés de cellules souches agissant comme des « éponges » absorbant les signaux...
Une expérience sur des méduses et des anémones de mer révèle que leurs cycles de sommeil présentent des similitudes notables...
En passant en revue plus de 100 ans de recherches, un neuroscientifique suggère que le cortex cérébral n’est peut-être pas...
En analysant 25 ans de données pour tenter de percer les secrets des « SuperAgers », ces personnes dotées d’une...